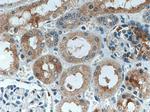
MIB1 Antibody in Immunohistochemistry (Paraffin) (IHC (P))

Search
Proteintech
MIB1 Polyclonal Antibody
{{$productOrderCtrl.translations['antibody.pdp.commerceCard.promotion.promotions']}}
{{$productOrderCtrl.translations['antibody.pdp.commerceCard.promotion.viewpromo']}}
{{$productOrderCtrl.translations['antibody.pdp.commerceCard.promotion.promocode']}}: {{promo.promoCode}} {{promo.promoTitle}} {{promo.promoDescription}}. {{$productOrderCtrl.translations['antibody.pdp.commerceCard.promotion.learnmore']}}
产品信息
11893-1-AP
种属反应
宿主/亚型
分类
类型
抗原
偶联物
形式
浓度
规格
纯化类型
保存液
内含物
保存条件
运输条件
产品详细信息
Immunogen sequence: LRHHTLSQL RQLQDMQDVG KVDAAWEPSK NTLIMGLGTQ GAEKKSAASI ACFLAANGAD LSIRNKKGQS PLDLCPDPNL CKALAKCHKE KVSGQVGSRS PSMISNDSET LEECMVCSDM KRDTLFGPCG HIATCSLCSP RVKKCLICKE QVQSRTKIEE CVVCSDKKAA VLFQPCGHMC ACENCANLMK KCVQCRAVVE RRVPFIMCCG GKSSEDATDD ISSGNIPVLQ KDKDNTNVNA DVQKLQQQLQ DIKEQTMCPV CLDRLKNMIF LCGHGTCQLC GDRMSECPIC RKAIERRILL Y (707-1006 aa encoded by BC022403)
靶标信息
MIB is an E3 ubiquitin-protein ligase that mediates ubiquitination of Delta receptors, which act as ligands of Notch proteins. This protein positively regulates the Delta-mediated Notch signaling by ubiquitinating the intracellular domain of Delta, leading to endocytosis of Delta receptors. MIB probably mediates ubiquitination and subsequent proteasomal degradation of DAPK1, thereby antagonizing anti-apoptotic effects of DAPK1 to promote TNF-induced apoptosis.
仅用于科研。不用于诊断过程。未经明确授权不得转售。
生物信息学
蛋白别名: DAPK-interacting protein 1; DIP-1; E3 ubiquitin-protein ligase MIB1; Mind bomb homolog 1; mindbomb E3 ubiquitin protein ligase 1; RING-type E3 ubiquitin transferase MIB1; ubiquitin ligase mind bomb; unnamed protein product; Zinc finger ZZ type with ankyrin repeat domain protein 2
基因别名: DIP-1; DIP1; KIAA1323; LVNC7; MIB; MIB1; ZZANK2; ZZZ6
UniProt ID: (Human) Q86YT6
Entrez Gene ID: (Human) 57534